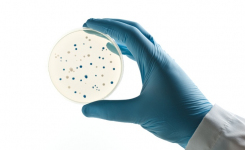
Improved recovery of ESBL-producing bacteria using chromogenic agar

Food & Beverage Clinical & Veterinary Microbiome
Journal Club: clinical
Join Our Journal Club - Understand Emerging Trends and Breakthrough DiscoveriesView by sector:
Go
Food & Beverage Clinical & Veterinary Microbiome
Clinical & Veterinary
Clinical & Veterinary
Clinical & Veterinary